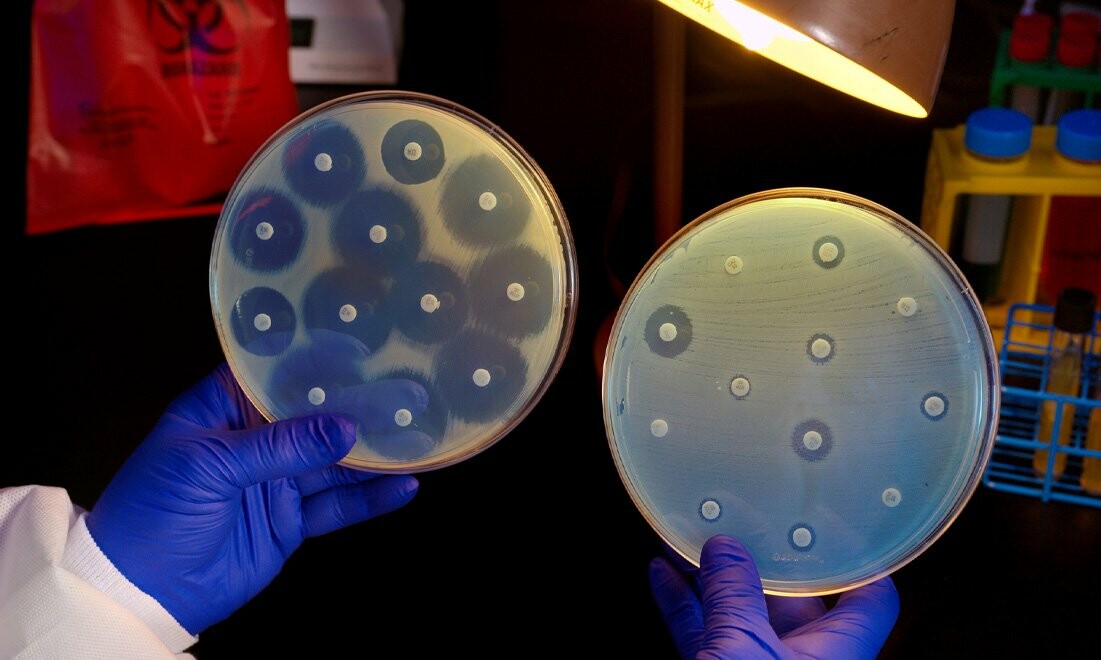

Идентификация бактерий — важный этап в микробиологических исследованиях, позволяющий определить видовую принадлежность микроорганизмов, выделенных из образцов окружающей среды, воды, пищевых продуктов, медицинского или промышленного оборудования. Правильно подобранная питательная среда является ключом к успешному росту, выделению и распознаванию бактерий. Чтобы простая среда микробиология была эффективной, важно заказывать ее в проверенном месте.
Идентификация бактерий — важный этап в микробиологических исследованиях, позволяющий определить видовую принадлежность микроорганизмов, выделенных из образцов окружающей среды, воды, пищевых продуктов, медицинского или промышленного оборудования. Правильно подобранная питательная среда является ключом к успешному росту, выделению и распознаванию бактерий. Чтобы простая среда микробиология была эффективной, важно заказывать ее в проверенном месте.
Особенности и основные отличия сухих сред
Среди множества типов питательных составов особое значение занимают сухие питательные среды. Эти среды представляют собой предварительно обезвоженные компоненты, которые сохраняются в герметичных упаковках и активируются путем добавления дистиллированной воды перед использованием.
Они отличаются высокой стабильностью при хранении, легкостью в транспортировке и точностью при приготовлении. Благодаря этим свойствам сухие питательные среды активно применяются как в лабораториях, так и на предприятиях, где важно обеспечить стабильность микробиологического контроля.
Простая среда в микробиологии используется для культивирования неприхотливых микроорганизмов. Такие составы содержат базовые источники углерода, азота и минеральных солей. Они идеальны для наращивания биомассы, базового изучения роста бактерий или в качестве основы для приготовления селективных и дифференциальных сред.
Преимущества применения
Среди основных плюсов можно отметить:
- Обеспечивают стабильный рост бактерий в условиях лаборатории.
- Подходят как для выделения аэробных, так и анаэробных форм микроорганизмов.
- Простота приготовления — добавление воды и стерилизация позволяет быстро получить готовый состав.
- Идеальны для рутинных микробиологических анализов, в том числе контроля санитарного состояния.
- Позволяют проводить идентификацию бактерий по морфологическим, биохимическим и физиологическим признакам.
- Активно применяются в пищевой промышленности, фармацевтике, ветеринарии, медицине, сельском хозяйстве.
- Устойчивы при длительном хранении, не требуют особых условий транспортировки.
- Подходят для использования в экспресс-лабораториях, выездных мобильных пунктах контроля и в учебных целях.
Они невероятно важны в современной микробиологии, позволяя проводить быструю и эффективную идентификацию бактерий в различных условиях. Они являются неотъемлемым инструментом санитарно-гигиенического контроля, научных исследований, производственного контроля и образовательного процесса.



